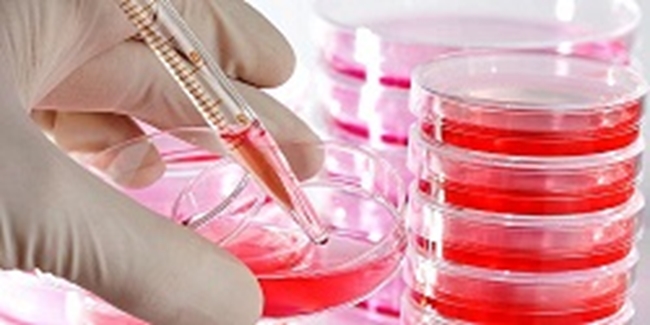
cell.jpg

برگزاری کارگاه
برگزاری مجدد کارگاه کشت سلولی در اردیبهشت ماه
مرکز تحقیقات سلولی مولکولی برگزارمیکند(دوره مجدد کشت سلولی )

مرکز تحقیقات سلولی مولکولی برگزارمیکند(دوره مجدد کشت سلولی )
تغییر اندازه فونت:
تغییر فاصله بین کلمات:
تغییر فاصله بین خطوط:
تغییر نوع موس:
تغییر فونت:
تغییر رنگ ها:
رنگ اصلی:
رنگ دوم:
رنگ سوم:
نظر دهید